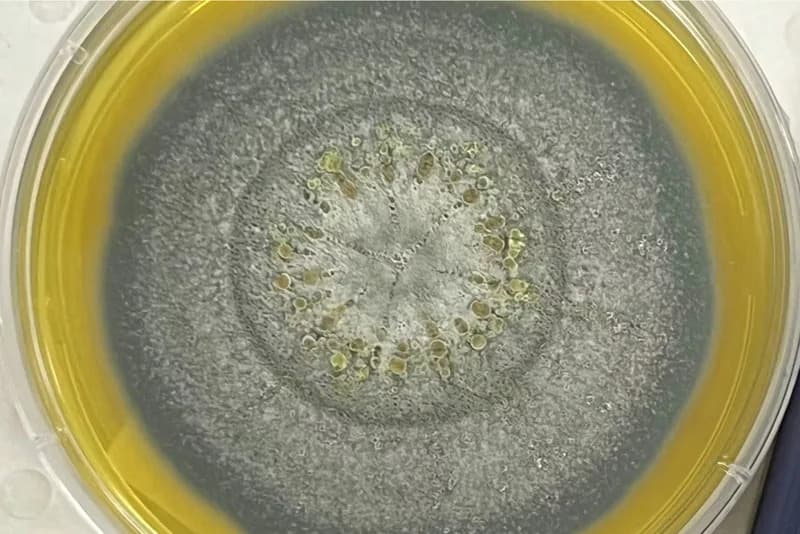
Gljiva iz NASA čistih prostorija može da preživi put do Marsa — šta to znači za planetarnu zaštitu?

Ukrajina je završila popravke na oštećenoj deonici naftovoda Družba i tvrdi da je sistem spreman za obnavljanje protoka, ali bez garancije od novih napada. Popravke su povezane sa očekivanjem da će EU odobriti paket pomoći od 90 milijardi evra, koji su ranije blokirale Mađarska i Slovačka. EU zvaničnici su oprezno optimistični da bi dogovor mogao biti postignut u roku od 24 sata dok se evropski ambasadori spremaju za sastanak.
Ukrajina Završila Popravke Naftovoda Družba, Odblokada EU Paketa Na Vidiku

Kijev, Ukrajina — Ukrajinski predsednik Volodymyr Zelenskyy saopštio je da su završene popravke na oštećenoj deonici naftovoda Družba i da je sistem spreman za obnavljanje protoka, uz upozorenje da ne postoji garancija da neće uslediti novi napadi.

Popravke su postale ključna tačka političkog spora koji je odlagao odobrenje velikog paketa pomoći Evropske unije vrednog oko 90 milijardi evra, namenjenog za podršku Ukrajini u naredne dve godine. Mađarska i Slovačka su ranije blokirale isplatu sredstava, pozivajući se na bezbednosna i energetska pitanja.

„Ukrajina je završila radove na deonici naftovoda Družba koja je bila oštećena ruskim udarom. Naftovod može nastaviti rad“, rekao je Zelenskyy na platformi X, dodavši:"Iako niko ne može garantovati da Rusija neće ponoviti napade, naši stručnjaci su obezbedili osnovne uslove za obnovu rada sistema i opreme."
Ruske isporuke nafte ka Mađarskoj i Slovačkoj bile su obustavljene već oko dva meseca nakon udara bespilotnim letelicama koje su, kako ukrajinski zvaničnici navode, oštetile ceo sistem na teritoriji Ukrajine. Kontinuirani napadi, prema tim izvorima, dovode u opasnost živote tehničara koji rade na popravci.

Visoki zvaničnici EU izrazili su oprezni optimizam da bi paket pomoći mogao biti odobren vrlo brzo — moguće već u roku od 24 sata — čime bi bio rešen višemesečni politički zastoj. Šefica spoljne politike EU Kaja Kallas rekla je novinarima u Luksemburgu da se očekuje dogovor, dok će se evropski ambasadori sastati kako bi finalizovali detalje.

Predsednik Evropskog saveta Antonio Costa zahvalio se Zelenskyyu putem društvenih mreža „što je ispunio dogovor: popravio naftovod Družba i vratio ga u rad“. EU je prvobitno nameravala da koristi zamrznuta ruska sredstva kao kolateral za zajam, ali je ta opcija naišla na prepreke u Belgiji, gde se nalazi najveći deo tih sredstava.
U decembru su Češka, Mađarska i Slovačka postigle dogovor da neće sprečavati ostale zemlje članice da pozajmljuju sredstva na međunarodnim tržištima, pod uslovom da te tri zemlje ne budu obavezane da učestvuju u mehanizmu. Kasnije je došlo do zaoštravanja, a spor oko naftovoda dodatno je produbio tenzije pred nedavne izbore u Mađarskoj.
Kontekst: Rat koji je počeo ruskom invazijom u februaru 2022. već je izazvao velike ljudske i materijalne posledice širom Ukrajine, a pitanja energetskog tranzita i bezbednosti infrastrukture ostaju u fokusu evropske politike.
Pomozite nam da budemo bolji.